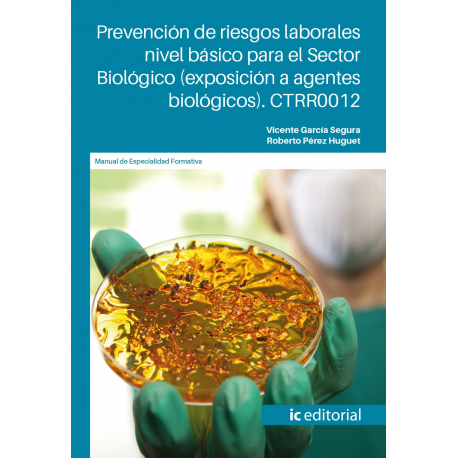
Prevención de riesgos laborales nivel básico para el Sector Biológico (exposición a agentes biológicos). CTRR0012

Producto añadido correctamente a su carrito de la compra
Hay 0 artículos en su carrito. Hay 1 artículo en su cesta.
Categorías
-
Capacitación profesional
- Administración y gestión
- Agraria
- Artes gráficas
- Comercio y marketing
- Derecho
- Desarrollo web - multimedia
- Diseño CAD
- Diseño gráfico
- Docencia - Pedagogía
- Edificación y obra civil
- Electricidad y electrónica
- Energía y agua
- Fabricación mecánica
- Formación complementaria
- Fotografía
- Habilidades directivas
- Hostelería y turismo
- Idiomas
- Imagen personal
- Industrias alimentarias
- Informática y comunicaciones
- Instalación y mantenimiento
- Medio ambiente
- Sanidad
- Seguridad
- Servicios socioculturales
- Social Media
- Tarjeta Profesional de la Construcción
- Transporte y mantenimiento de vehículos
- Veterinaria y cuidado de animales
-
Certificado de profesionalidad
- Actividades físicas y deportivas
- Administración y gestión
- Agraria
- Artes Gráficas
- Comercio y marketing
- Edificación y obra civil
- Electricidad y Electrónica
- Energía y agua
- Fabricación mecánica
- Hostelería y turismo
- Imagen personal
- Industrias alimentarias
- Industrias extractivas
- Informática y comunicaciones
- Instalación y mantenimiento
- Madera, mueble y corcho
- Química
- Sanidad
- Seguridad y medio ambiente
- Servicios socioculturales y a la comunidad
- Textil, confección y piel
- Transporte y mantenimiento de vehículos
-
Especialidades formativas
- Administración y gestión
- Agraria
- Artes gráficas
- Artes y artesanía
- Comercio y marketing
- Competencia Transversal
- EDIFICACIÓN Y OBRA CIVIL
- Electricidad y electrónica
- Energía y agua
- Fabricación mecánica
- Formación complementaria
- Hostelería y turismo
- Industrias alimentarias
- Informática y telecomunicaciones
- INSTALACIÓN Y MANTENIMIENTO
- Sanidad
- Seguridad y medio ambiente
- Servicios socioculturales
- Textil, confección y piel
- Transporte y mantenimiento de vehículos
Tus últimas consultas
-

Prevención de riesgos...
Autores: Vicente García Segura,...
¡Lo más vendido!
-

-

Operaciones auxiliares de almacenaje MF1325_1
Autor: Federico Serrano AlonsoPáginas: 330ISBN: 978-84-9198-692-8Fecha...
30,58 € -

Rescate de accidentados en instalaciones acuáticas MF0271_2 (2ª Ed.)
Autora: Rosario Olmedo JaraPáginas: 230ISBN: 978-84-9198-825-0Fecha...
21,11 €
Prevención de riesgos laborales nivel básico para el Sector Biológico (exposición a agentes biológicos). CTRR0012
126384
Autores: Vicente García Segura, Roberto Pérez Huguet
Páginas: 262
ISBN: 979-13-7027-108-4
Fecha publicación: 02/01/2026
Edición: 1
Libro color
Más
OBJETIVOS
- Aplicar los conceptos en materia de prevención de riesgos laborales (PRL), generales y específicos, que acerquen al conocimiento de la ley, de los derechos y obligaciones legales, de los riesgos y de las medidas preventivas.
- Identificar la normativa, las responsabilidades, los derechos y las obligaciones de empresarios, mandos y trabajadores en materia de prevención, comprendiendo los conceptos básicos sobre seguridad y salud en el trabajo.
- Diferenciar los riesgos generales en el entorno laboral y su prevención, las actuaciones preventivas básicas, su seguimiento y el control de las evaluaciones elementales de riesgos.
- Identificar los derechos y obligaciones de los trabajadores en relación con la seguridad y la salud en el trabajo, a fin de tomar conciencia sobre la importancia de involucrarse en la PRL.
- Establecer las pautas de la prevención en las actuaciones de primeros auxilios, emergencia y evacuación.
- Identificar y analizar los principales riesgos asociados al sector de la alta tensión, prestando especial atención a los riesgos específicos de mayor relevancia.
CONTENIDOS
Identificación de los conceptos de seguridad y salud en el trabajo
Trabajo y la salud (riesgos profesionales y factores de riesgo)
Daños derivados del trabajo. (Los accidentes de trabajo y las enfermedades profesionales). Otras patologías derivadas del trabajo.
Marco normativo básico en materia de prevención de riesgos laborales. Derechos y deberes básicos en materia preventiva
Diferenciación de riesgos generales y su prevención
Evaluación de riesgos. Gestión de las condiciones de seguridad
Interpretación de riesgos del medio ambiente de trabajo
Análisis a la carga de trabajo, fatiga e la insatisfacción laboral
Identificación de los sistemas elementales de control de riesgos. Aplicación de los medios de protección colectiva. Manipulación de equipos de protección individual. Señalización de seguridad
Introducción a la gestión de la Prevención de Riesgos Laborales
Organismos públicos relacionaos con la Seguridad y Salud en el trabajo
Organización del trabajo preventivo. Rutinas básicas
El sistema de Prevención de Riesgos Laborales. Evaluación, planificación y documentación (recogida, elaboración y archivo)
Gestión de la Prevención de Riesgos Laborales
Representación de los trabajadores
Coordinación de actividades empresariales
Descripción del recurso preventivo
Clasificación de los organismos públicos
Representación de rutinas básicas
Elementos básicos de primeros auxilios
Análisis primeros auxilios y salud
Procedimiento general RCP-CAB
Control de salud
Actuación de emergencia y evacuación
Emergencias y evacuación
Plan de autoprotección
Riesgos específicos y su prevención en el sector biológico
Importancia de la prevención en el entorno laboral y ambiental
Principios de la acción preventiva
Identificación de los riesgos específicos del sector biológico
Ligados a las condiciones de seguridad
Ligados al medio ambiente de trabajo y organizativos en el sector biológico
Distinción de otros riesgos (ergonómicos y psicosociales)
Aplicación de medidas preventivas específicas del sector biológico
Medidas técnicas
Medidas organizativas
Medidas ambientales
Protección colectiva
Protección individual (Equipos de Protección Individual)
Normativa aplicable en materia de prevención en el sector de la alta tensión
Legislación nacional
Legislación europea e internacional
Normativa internacional y guías técnicas
Riesgos específicos por puesto de trabajo
Investigador en biología molecular y celular
Microbiólogo
Biotecnólogo
Especialista en genética
Especialista en bioinformática
Procedimientos de actuación en caso de accidente o emergencia biológica
Clasificación de daños y emergencias más frecuentes en el sector biológico
Protocolos de intervención y contención ante accidentes laborales y ambientales
Organización de la evacuación y atención a las víctimas
Protocolos de comunicación en situaciones de emergencia
Reseñas
No hay reseñas de clientes en este momento.










